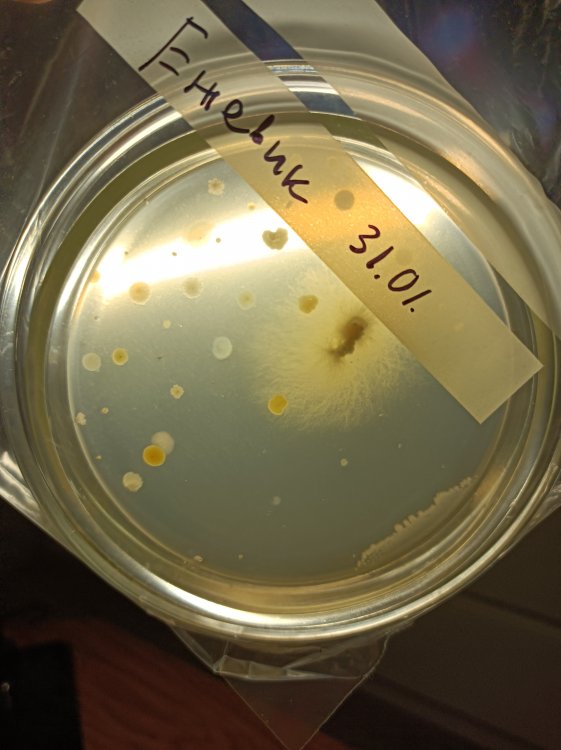
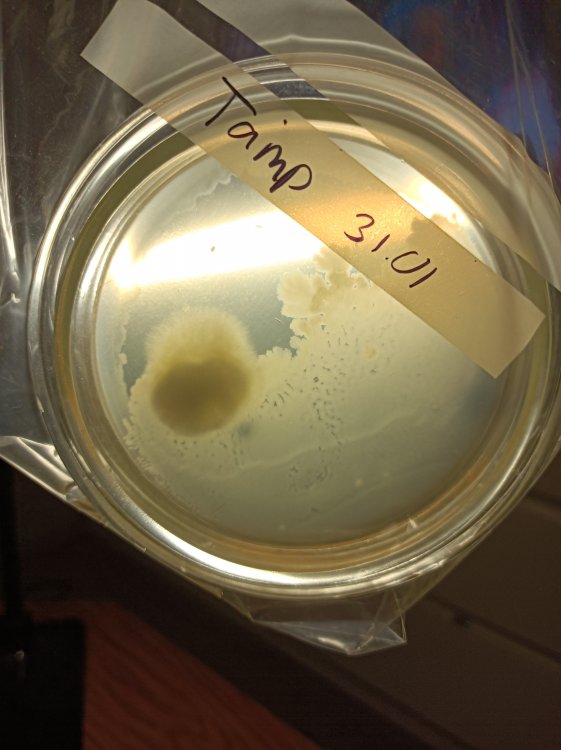

-
Публикаций
77 -
Зарегистрирован
-
Посещение
-
Победитель дней
17
Весь контент Judar7
-
Пришло лето и грибы дали заднюю, самый большой гриб выше на фото, остальные остановились в росте... Ещё есть надежды на ежовик... А с остальными, наверно, продолжу ближе к осени.
- 31 ответ
-
- 1
-

-
- ежовик гребенчатый
- львиная грива
- (и ещё 7 )
-
Во, еще пару-тройку таких и можно жарить картошечку с грибами. По вкусу напоминает вешенку, но есть некая сладость, говорят после термообработки будет еще вкуснее. Растите гигантские вкусные грибы у себя на балконе
- 31 ответ
-
- 3
-

-

-
- ежовик гребенчатый
- львиная грива
- (и ещё 7 )
-
Кейк и доставать не пришлось, стояла прохладная пасмурная погода, и весь кейк покрылся маленькими грибочками, которые ещё вчера были пинами - еле заметными точками. Один богатырь уже шляпу раскрыл правда в одну сторону, подожду ещё, понаблюдаю когда лучше снимать урожай. Температура попадает в пределы +16 градусов, либо ночью если на улице теплее, либо днём когда пасмурно. Но если лето разгуляется и будет жара, то наверное усё затормозится до осени.
- 31 ответ
-
- 3
-

-

-
- ежовик гребенчатый
- львиная грива
- (и ещё 7 )
-
Жаль, что не удалось наладить условия для круглогодичного грибоношения, но несколько раз в год урожаем себя можно побаловать. Растут шимеджики, интересно будет после волны достать кейк, потому, что грибы растут прям с мицелия, из под покрова не вылазят совсем.
- 31 ответ
-
- 3
-

-
- ежовик гребенчатый
- львиная грива
- (и ещё 7 )
-
Я уж думал, что тема загнулась, как и многие подобные... Но сегодня случилось приятное проишествие! По порядку: не удалось мне создать необходимый микроклимат, и винный шкаф - затея не дешёвая, да и купить его оказалось проблемно в плане доставки. Вернее доставка выходит дорогая если шкаф дешёвый, так что проще купить дорогой, но денег жалко, ведь перспективы сомнительные. Ежовик в четырех банках захватил весь рис, сперва елеуловимым пушком, а затем медленно но верно наращивал темп. Хотел я хотя бы мицелия нарастить, но не тут то было, а плодовые тела ежа уже в банках начали расти. Вобщем я забросил всё это на самотёк. Шимеджи - очень активный мицелий, лучше и быстрее всех себя показал, но плодоносить при комнатной температуре не стал. Я его по методу кейсинга, как кубы, поставил и ждал примерно месяц, после убрал в холодильник. И вот спустя время решил, что терять мне уже не чего, а выкидывай жалко, я выставил повторно шимеджи на плодоношение, а парник поставил на балкон, температура там колеблется от -9 ночью, до +20 днём, лето не жаркое выдалось. Вобщем все новости на фото ниже... Решил и ежа выставить прям банки в контейнере, для получения плодовых тел, посмотрим, что получится. Хотя еж и при комнатной температуре давал бы урожай. Так, что не все потеряно оказалось. Вишенку попробую ближе к осени выставить на балкон и шиитаке возможно тоже.
- 31 ответ
-
- 4
-

-

-
- ежовик гребенчатый
- львиная грива
- (и ещё 7 )
-
Как видно выше, Б+ принт выдохся и кроме бактериалки ничего не дал. Ну и земля ему пухом, хорошие были грибы. ЖМ в шприцах шимеджи и эринги, понравилась им резинка на поршне, они её прям облепили. Наверное кушают её. На фото Эринги. В большом шприце рассадник мица Ежа, в малом нижнем тоже миц Ежа но после пересадки из большого. Вобщем весь пересаженый миц ушёл в банку с рисом. Очень надеюсь на успех. Пойду бить в бубен.
- 31 ответ
-
- 1
-

-
- ежовик гребенчатый
- львиная грива
- (и ещё 7 )
-
Всем трям! Хорошие новости: - в одном из шприцев еж все-таки дал мицелий после ощипывания/разрывания. Переинокулировал банку с бурым рисом, теперь снова ждём. - банка с шиитаки на буром рисе отлично пушится, не быстро, но радуют положительные тенденции! Инокулировал ещё две банки с рисом, это всё те-же банки от 6го января, стояли в холодильнике и ничего в них не растёт ненужного, что тоже несомненно радует! Итак, в одну банку посадил Шимеджи, в другую Эринги, все четыре штамма засели на одинаковые условия и среду. Посмотрим, что же будет дальше. Отчёт об агаре. Контрольная чашка показала себя достойно в сравнении с остальными. Нужна уф лампа для дезенфекции глава с перчатками, протирания спиртом не хватает. Нужно прикупить мини-пульвик, залить туда спирт или что-то полегче и опрыскивать перед работой обильно прям в главе. Там и так мало места для работы, нужно разработать эффективную последовательность действий в главе. Минимизировать лишние движения. Фото с чашками ниже.
- 31 ответ
-
- ежовик гребенчатый
- львиная грива
- (и ещё 7 )
-
Пакеты которые для запекания хуже всех себя показали, в них действительно каким-то образом попадает вода, я так и не понял, все в утиль. Поэтому гайд по пакетам для замарозки остаётся актуальным. Вот тампы у меня были в таких пакетах для заморозки, после полного обрастания, я честно тупанул, и переломал мицелий, а он не стал срастаться снова, я переживал, что у меня зерно подсохло и бахнул туда воды стерильной, но получил закись по зерну, оно как-бы начало задыхаться там. Выбрал куски самые большие от туда и закинул в контейнер под кокос, а одно зернышко на агар.
- 31 ответ
-
- ежовик гребенчатый
- львиная грива
- (и ещё 7 )
-
У меня есть одна контрольная чашка, которую я не открывал даже, после остывания в ней агара. Она чистая. А те, в которые пересадку делал, занёс "инфекцию". Прошло четыре дня, в понедельник покажу результаты.
- 31 ответ
-
- 1
-

-
- ежовик гребенчатый
- львиная грива
- (и ещё 7 )
-
Fera Genetics советывали юзать солодовый агар для ежа, пока в эту тему не углублялся.
- 31 ответ
-
- ежовик гребенчатый
- львиная грива
- (и ещё 7 )
-
Тишина пока в банках ни ежа, ни шиитаке, а чашки петри покрываются разноцветными пятнами. Думаю лампу УФ покупать для главабокса, обработки антисептиком оказалось мало. Хорошие новости, что тампы живы, зерно подкисло в пакете, но часть удалось спасти и покейсить.
- 31 ответ
-
- 2
-

-

-
- ежовик гребенчатый
- львиная грива
- (и ещё 7 )
-
Да бро, подкоплю ещё сверху лампу УФ положу. Цена такого мини - 300 - 350₽ в общем. С лампой 1300₽, но польза покрывает все расходы...думаю. Желательно ток контейнер брать с прямой поверхностью, через ребристую крышку не видать ничего.
- 31 ответ
-
- 1
-

-
- ежовик гребенчатый
- львиная грива
- (и ещё 7 )
-
Всем привет! Вобщем ёжик подводит меня. Тот, что пришёл на агаре начал плодоностить, и не особо хочет расти в форме мицелия. Провел сегодня две пересадки в шприц на ЖМ и на агар. Был приготовлен агар из отвара ржи озимой и меда, слабый, но на вкус чувсвовалась лёгкая сладость - присутствие меда. По совету Федота сдедал саб, или как его там... Чашки упаковывал в крафт пакеты и стерилизовал в сухожаровом шкафу. Любимая профессионально занимается когтями. Позже разливал всё в сабе, предварительно обработав антисептиком и спиртом. Как буду богаче, куплю УВ лампу. В чашки кинуты - ёжик, зерно тампаненсисов заражённое мицелием из пакета, что после перемешивания не стал срастаться. Взвесь Б+ старого принта, решающая попытка реанимации. Одна чашка пустая - контрольная. Заразил две банки с бурым рисом, одну ёжиком, вторую шиитаки. Много работы проделана, ждём, и скоро будем пожинать плоды...
- 31 ответ
-
- 3
-

-
- ежовик гребенчатый
- львиная грива
- (и ещё 7 )
-
И чего же в ней мистического кроме этого длинного, красноречивого, загадочного текста? Причём всё в кучу... Дунуть табака в нос, чтоб открылся третий глаз Состав надо смотреть, что туда входит и как действует...
-
Да, дело то не быстрое, как оказалось. И я уже заскучал, по сему сделал ещё пару пакетов с рисом и пару пакетов с овсом. Рис я использую бурый с целью получения мицелия. А овёс нешелушеный думаю отлично подойдёт для маточного мицелия вешенки и шимеджи, и последующих замесах с опилками и сеном. К тому же пришли мне стеклянные чашки Петри, приготовлен отвар риса и овса, чё добру проподать. Буду пастеризовать их в скором времени. Планы на них такие... Есть у меня взвесь старого Б+, хочу реанимировать, может почистить придётся, так как принт мой и вроде, как третьего или четвёртого поколения. Когда-то с них всё началось... Принту четыре года, думал он уже не рабочий, но по факту в шприце плавает ЖМ. Пересадить Ежа, он вобще интересно миц ростит - каралами, но совсем не быстро. Думаю самый резоморф отщипить и кинуть в чашку. Есть у меня два пакета тампов, в процессе склерообразования, а принтов не осталось, жиденький был один, нужно исправлять ситуацию... Пока как-то так, скоро надеюсь дело пойдёт быстрее. Фоточки с развитием ЖМ прилагаю
- 31 ответ
-
- 4
-

-

-
- ежовик гребенчатый
- львиная грива
- (и ещё 7 )
-
Приветствую, пришли мне штаммы от Fera Genetics. Заказывал у них впервые, плюс в том, что при заказе трех культур, четвёртую мне подарили. Минусы: заказывал ЖМ, пришли на агаре, ЧП с ежом треснула при доставке. Сегодня сделал четыре шприца, в надежде получить ЖМ. Вода для инъекций + глюкоза 5% ~1-3 мл. Технолог их показывал, что на глюкозе аптечной у них ЖМ нормальными хлопьями развивается, но решил концентрацию сахара понизить. Приготовлены четыре банки с бурым рисом для пастрезации, остатки засунул в пакет, туда же закинул кусочки рейки деревянной. Три банки и пакет под ежевик, одину банку под шиитаки. Остальные жильцы будут дождаться "винного шкафа" так, как их мецелий не интересен, а пока нет возможности создать условия. По ходу процесса буду дополнять репорт...
- 31 ответ
-
- 7
-

-

-
- ежовик гребенчатый
- львиная грива
- (и ещё 7 )
-
Сегодня заказал себе ежовик, шимеджи, шиитаки и еренге ЖМ'ом. Буду гровить в новом году.
-
Я как увидел эти шимеджи, сразу влюбился, жаль у нас не продают в магазинах их. Но знаю где ЖМ достать
-
Жаль, что человек потерялся, видимо объелся грибами и не хочет делиться, очень вкусные